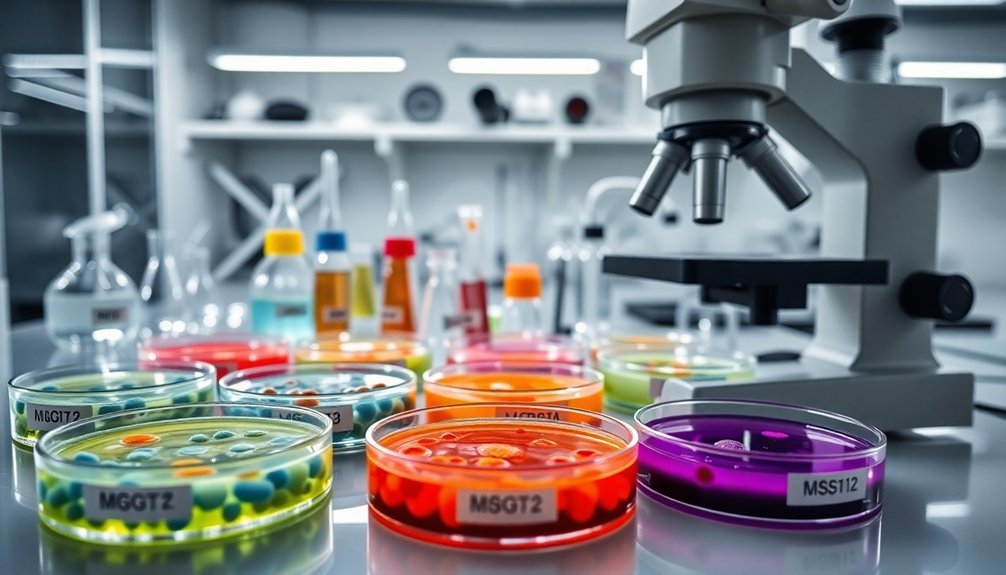

Five essential laboratory tests for natural preservative methods include challenge testing to verify antimicrobial efficacy, pH stability analysis to guarantee preservation within ideal ranges (3.5-6.0), accelerated aging protocols to simulate long-term stability, microbial enumeration techniques following USP 61 standards, and extraction protocol validation to maintain natural preservative potency. You'll need specialized equipment like calibrated pH meters, incubators, and appropriate growth media. These scientific approaches will transform your natural formulation efforts from guesswork to validated preservation systems.
5 Laboratory Tests For Natural Preservative Methods

When establishing effective laboratory testing for natural preservatives, researchers must implement rigorous protocols that assure reliable and reproducible results.
You'll need specialized extraction methods to maintain the efficacy of preservatives sourced from plants, essential oils, and other natural origins.
Your laboratory setup should include advanced equipment for microbial enumeration and analysis, which helps quantify viable organisms before and after preservation treatment.
Modern microbial enumeration equipment is essential for accurately quantifying organism populations throughout the preservation testing process.
Proper sample preparation is critical for accurate results. You'll also need to implement statistical tools to analyze growth patterns and monitor for potential microbial resistance.
Don't overlook regulatory compliance—international guidelines from ISO, USP, and EP are necessary for market access. These standards are essential to verify that natural preservatives can effectively inhibit microbial growth in various product formulations.
Document your procedures carefully to guarantee standardization across testing phases, and utilize collaborative platforms to enhance efficiency when working with research partners.
Challenge Testing: Evaluating Antimicrobial Efficacy in Soap Formulations
Why does challenge testing represent the gold standard for evaluating preservative systems in soap formulations? It provides objective data on a preservative's ability to combat microbial contamination throughout a product's shelf life, ensuring both regulatory compliance and consumer safety.
When you conduct challenge tests, you'll expose your soap formulations to specified microorganisms under controlled conditions that simulate real-world use. Natural preservatives often exhibit pseudoplastic behavior, which influences their distribution and efficacy throughout the soap matrix.
| Test Parameter | Standard Method | Natural Preservative Consideration |
|---|---|---|
| Microorganisms | *E. coli*, *S. aureus*, *P. aeruginosa* | May require additional fungi testing |
| Test Duration | 28 days typical | May need extended periods |
| Temperature | 32.5°C standard | Multiple temperatures recommended |
| Success Criteria | Log reduction within timeframe | May show slower but sustained activity |
Your formulation passes when it demonstrates sufficient reduction in microbial counts within the prescribed testing period.
Ph Stability Analysis for Natural Preservative Systems

Although natural preservatives offer compelling alternatives to synthetic options, their effectiveness hinges critically on maintaining proper pH levels throughout a product's lifecycle. Most natural preservatives work best between pH 3.5-6.0, with specific ranges for each agent.
Natural preservation success depends on pH stability—most effective between 3.5-6.0 with agent-specific optimal ranges.
When conducting pH stability analysis, you'll need to:
- Utilize accurate pH meters with regular calibration to guarantee precise measurements
- Implement titration techniques to determine the exact pH of your formulation
- Test preservative efficacy at various pH points within your product's expected range
- Monitor pH stability over time using buffer solutions to identify potential drift
Remember that formulations outside best pH ranges can lead to preservative failure or product destabilization.
Natural preservatives like benzoic and sorbic acids are only effective in their undissociated acid forms at specific pH levels. This limitation makes it essential to consider packaging compatibility as certain materials may influence pH over time, potentially compromising preservative performance.
Accelerated Aging Protocols for Traditional Soap Preservation
Beyond pH considerations, establishing reliable accelerated aging protocols represents the next critical step in validating natural soap preservation methods.
You'll need to manipulate key stressors including temperature (typically 100°C), humidity (around 85%), and UV exposure to simulate long-term environmental impacts in compressed timeframes.
Select protocols adapted from literature that align with traditional soap properties, ensuring you maintain proper control conditions (20±2°C, 55% RH) for comparison.
Your assessment toolkit should include optical microscopy for morphological changes, thermogravimetry for stability evaluation, and FTIR spectroscopy to detect chemical alterations.
Material composition greatly influences aging dynamics, with additives and pigments potentially forming metal soaps and oxalates.
While these protocols efficiently predict long-term viability, remember to validate accelerated findings against real-time aging when possible.
Microbial Enumeration Techniques for Artisanal Soap Quality Control
When implementing natural preservation methods in artisanal soaps, accurate microbial enumeration becomes essential for validating product safety and stability.
You'll need to follow standardized testing protocols like USP 61 to guarantee your handcrafted products meet regulatory requirements.
For effective microbial enumeration in your artisanal soaps:
- Use Soybean-Casein Digest Agar for TAMC testing to accurately count aerobic bacteria present in your formulations.
- Employ Sabouraud Dextrose Agar specifically for detecting and quantifying yeasts and molds (TYMC).
- Implement proper neutralization techniques when testing soaps with antimicrobial ingredients to prevent false negatives.
- Perform tests in duplicate using both plate count and membrane filtration methods for thorough quality control.
These techniques will help you verify that your natural preservation methods deliver the <200 CFU/ml levels required for sensitive products. The alkaline environment with pH of 10 in biosurfactant-based soaps contributes to their antimicrobial effectiveness against pathogenic bacteria.
Frequently Asked Questions
How Do Natural Preservatives Interact With Essential Oil Fragrances?
Natural preservatives can enhance essential oil fragrances through synergistic effects, while the oils themselves contribute preservative qualities. You'll find they work together, often complementing each other's antimicrobial properties and sensory profiles.
Can Microbial Resistance Develop Against Multiple Natural Preservatives Simultaneously?
Yes, microbes can develop resistance to multiple natural preservatives simultaneously through co-resistance mechanisms. You'll find this happens when preservatives share similar targets or when bacteria evolve cross-adaptive responses to different antimicrobial compounds.
What Equipment Is Necessary for Small-Scale Preservative Testing?
You'll need an incubator, microbiological media, inoculation loops, HPLC or LC-MS for analysis, homogenizers for sample preparation, colony counters, and sterile containers. Don't forget positive cultures for challenge testing your preservatives.
How Does Water Activity Affect Natural Preservative Performance?
Lower water activity enhances your natural preservatives' effectiveness. When you reduce available water below 0.600, you'll limit microbial growth, potentially decreasing the amount of preservatives needed while extending your product's shelf life.
Are There Significant Differences in Testing Methods Between Global Regions?
Yes, you'll find substantial regional differences in testing methods. North America and Europe favor rigorous challenge testing, while Asian and African regions often implement more flexible protocols based on local regulations and cultural preferences.
In Summary
You've now explored five essential lab tests for natural preservatives in soap making. By implementing challenge testing, pH stability analysis, accelerated aging protocols, and microbial enumeration techniques, you'll create safer, more stable products. Don't underestimate these scientific approaches—they're your best tools for verifying preservation efficacy while staying true to natural formulation principles. Your customers deserve products that are both natural and scientifically sound.





Leave a Reply